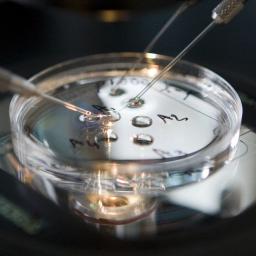

|
on (#3YFR5)
Japan werd vorige week opgeschrikt door een aardbeving met een kracht van 6,7. Meer dan 2.500 mensen verblijven nog steeds in opvangcentra.
|
 Nieuws, achtergronden en onderzoeksjournalistiek - NRC
Nieuws, achtergronden en onderzoeksjournalistiek - NRC
| Link | https://www.nrc.nl/ |
| Feed | http://www.nrc.nl/rss.php |
| Copyright | Mediahuis NRC BV, Amsterdam. Deze RSS-feed is uitsluitend bedoeld voor persoonlijk, niet-commercieel gebruik. Op ieder gebruik van RSS-feeds van NRC zijn de Leveringsvoorwaarden van toepassing: https: |
| Updated | 2025-11-24 02:30 |
 |
on (#3YFR7)
Asielzoekers moeten steeds langer wachten voordat hun asielaanvraag wordt beoordeeld. De wachttijd bedraagt nu vijf maanden.
|
 |
on (#3YFR9)
Lyor Cohen werkte decennialang met de grootste hiphopsterren. Nu wil hij als topman van YouTube de relatie tussen Google en de muziekindustrie verbeteren.
|
 |
on (#3YFRB)
Wie gaat solliciteren kan onderworpen worden aan een ‘assessment test’ – een test die meet hoe intelligent je bent en wat je eigenschappen zijn. Maar hoe betrouwbaar is dat?
|
 |
on (#3YFRD)
Beide coureurs reden op dat moment ongeveer 200 kilometer per uur. Ook bij het team dat Fenati voor komend seizoen heeft gecontracteerd, is hij niet langer welkom.
|
 |
on (#3YFKZ)
Het dreigingsniveau wordt niet verlaagd. De aanslag op het Centraal Station van Amsterdam illustreert volgens de NCTV de dreiging in Nederland.
|
 |
on (#3YFM1)
In een prachtige expositie toont Museum Boijmans Van Beuningen, in samenwerking met het Prado in Madrid, de onweerstaanbare olieverfschetsen van Peter Paul Rubens.
|
 |
on (#3YFG2)
Hij gaat bij Talpa grote studioshows presenteren en werkt aan een nieuw dagelijks programma.
|
 |
on (#3YFG4)
Justitie gaat na de witwasaffaire geen individuele bankiers vervolgen, maar advocaten willen dat er wel een tuchtzaak komt tegen de top van ING. Ze zijn een actie gestart.
|
 |
on (#3YFG6)
De veiligheidsdiensten grepen in nadat meerdere gewapende mannen al schietend het gebouw waren binnengedrongen. Er zijn zeker vier doden gevallen, onder wie twee aanvallers.
|
 |
on (#3YFD9)
Festival Amsterdam Fringe biedt „alles waar je niet op zit te wachtenâ€, aldus festivaldirecteur Aukje Verhoog. Ze schroefde het aantal voorstellingen omlaag, waardoor de kwaliteit verbeterde.
|
 |
on (#3YFDB)
Sint-Maarten, Saba en Sint-Eustatius moeten rekening houden met windkracht 12, zware regenval en metershoge golven.
|
 |
on (#3YFDD)
Dit staat in een speech die veiligheidsadviseur John Bolton maandag geeft. Ook zal hij zich in felle bewoordingen uitlaten over het Internationaal Strafhof (ICC).
|
 |
on (#3YFDF)
De inspectie vreest dat de verbetertrajecten in het ziekenhuis van Loek Winter onvoldoende aandacht zullen krijgen ‘gezien de huidige bestuurlijke onrust’.
|
|
on (#3YFG8)
Welke vragen vinden wetenschappers belangrijk om te onderzoeken maar doen ze nu niet doordat er geen geld voor is? Evelien Tonkens geeft de aftrap.
|
 |
on (#3YF8B)
Leslie Moonves, de machtige topman van de Amerikaanse tv-zender CBS, moet opstappen na beschuldigingen van twaalf vrouwen
|
 |
on (#3YF8D)
De commissie is een initiatief van Nederland en heeft tot doel overheden te overtuigen maatregelen te nemen tegen de gevolgen van klimaatverandering.
|
 |
on (#3YF66)
Filmster Sophia Loren (83) bezocht het Vlissingse festival Film By the Sea voor de uitreiking van de Grand Acting Award. „U bent allemaal zo aardig.â€
|
 |
on (#3YF3W)
Vandaag praat de Tweede Kamer met experts over of kinderen op school genoeg bewegen. Schrijf je in om deze politieke nieuwsbrief per mail te ontvangen.
|
 |
on (#3YF68)
Het American football-seizoen is pas net begonnen en er wordt nu al meer gesproken over knielende spelers dan over de uitslagen.
|
 |
on (#3YF3X)
Leerlingen moeten vaker opstaan, meer oefeningen doen en gebruik kunnen maken van een gevarieerd sportaanbod. Dat stellen drie belangrijke adviesraden.
|
 |
on (#3YF3Z)
Lili en Howick gaven na hun terugkeer het eerste interview aan het Jeugdjournaal. In de serie ‘Ik weet wie je bent’ probeert ook Daan Schuurmans moreel het juiste te doen.
|
 |
on (#3YF41)
Het vertrek van Leslie Moonves kwam enkele uren nadat zes vrouwen hem beschuldigden van seksueel wangedrag in het tijdschrift The New Yorker.
|
 |
on (#3YF1Z)
Na een jaar voorlopige hechtenis kwam Kem Sokha op borgtocht vrij. In de aanloop naar de Cambodjaanse verkiezingen werd hij ingerekend op verdenking van verraad.
|
 |
on (#3YEZT)
Volgens Amnesty International worden gevluchte Venezolanen standaard opgesloten in detentiecentra in afwachting van hun uitzetting.
|
 |
on (#3YERH)
De landbouw moet minder grondstoffen verspillen, zo schrijft minister Schouten in een visie. Maar hoe dan en wie betaalt dat?
|
 |
on (#3YERK)
Voor elk in de Tweede Wereldoorlog vanuit Vught gedeporteerd Joods kind een narcis. Ook het symbool voor alle kinderen die zich vandaag de dag in mensonwaardige omstandigheden bevinden.
|
 |
on (#3YERN)
Hebben westerse leiders geen spijt dat ze Libië in 2011 aan de genade van de milities hebben overgelaten, vraagt Carolien Roelants zich af.
|
 |
on (#3YENW)
In de hoogstaande mannenfinale in New York versloeg Novak Djokovic zijn Argentijnse tegenstander Juan MartÃn del Potro in drie sets.
|
 |
on (#3YENY)
De aanvaller had een mes en een ijzeren staaf en sloeg toe bij een bioscoop in het centrum van de Franse hoofdstad. De politie heeft hem overmeesterd.
|
 |
on (#3YEHS)
Het Zweedse politieke landschap raakte zondag versplinterd. Zowel de partijen op de linker- als de rechterflank boekten winst.
|
 |
on (#3YEF5)
Het Nederlands elftal ging in Parijs met 2-1 onderuit tegen wereldkampioen Frankrijk.
|
 |
on (#3YEF7)
De coalitie hield, ondanks hevige protesten, lang vast aan de strenge lijn: Lili en Howick moesten terug naar Armenië. Wat gebeurde er dit weekend?
|
 |
on (#3YEF9)
Kenta Tanaka is al tijden een ster in Japan en moet dat nu bij HGC worden. Een enorm cultuurverschil, maar hij past naadloos in het team.
|
 |
on (#3YECP)
De Zweden-Democraten zijn de grote winnaar van de verkiezingen met 18 procent van de stemmen. Het centrum-links en centrum-rechtse blok zijn ongeveer even groot geworden.
|
 |
on (#3YECR)
Topfavoriet Nairo Quintana kon dit weekeinde zijn slag niet slaan in de bergen. De Colombiaan verloor zelfs tijd op zijn concurrenten.
|
 |
on (#3YECT)
Een van de sprekers heet zelfs Jan Marijnissen, maar zegt er zelf bij geen familie te zijn.
|
 |
on (#3YE9D)
Serena Williams zal hoe dan ook de strijd weer aangaan met het establishment, ook al heeft ze soms ongelijk.
|
 |
on (#3YE6V)
“Na tien jaar met stress, onzekerheid, verdriet en boosheid leven, weten we nu dat alles gaat veranderenâ€, zegt Howick tegen het NOS Jeugdjournaal.
|
 |
on (#3YE9E)
Mac Miller was een jonge rapper van de oude stempel.
|
 |
on (#3YE3M)
Dat schrijven ministers Blok en Kaag in een brief aan de Tweede Kamer. Ook de steun aan hulpverleningsorganisatie Witte Helmen wordt stopgezet.
|
 |
on (#3YE3P)
Het festival liet grote rivaal Cannes dit jaar in het stof bijten met een formidabele line-up, Hollywoodglamour en vooral vernieuwing.
|
 |
on (#3YE3R)
De Japanse sensatie Naomi Osaka won van Serena Williams in een US Open-finale die voor altijd om de verkeerde redenen herinnerd zal worden.
|
 |
on (#3YE3T)
Er wordt gespeculeerd dat de voormalige minister van Buitenlandse Zaken binnenkort een leidersschapsstrijd met May wil openen.
|
 |
on (#3YE3W)
In de havenstad Hodeida zijn tijdens gevechten 73 Houthi’s gedood en zeker elf militanten van het pro-regeringsleger.
|
 |
on (#3YE0P)
Na een zichzelf opgelegde zomerpauze keert Jeroen Rauwerdink (donderdag 33) terug in het Nederlands team, voor zijn eerste WK.
|
 |
on (#3YDXE)
Drie inzittenden hebben de crash overleefd, onder wie een kind van zes jaar oud. De oorzaak van het ongeluk is nog niet helemaal duidelijk.
|
 |
on (#3YDXG)
Rusland en het regime van Assad hebben de aanval op de provincie Idlib geopend. Gevreesd wordt voor veel burgerdoden en nieuwe vluchtelingenstromen.
|
 |
on (#3YDV1)
De aanhangers van oppositiepoliticus Alexej Navalny grepen de regionale verkiezingen aan om te demonstreren tegen het verhogen van de pensioenleeftijd.
|
 |
on (#3YDR4)
In het Muziekgebouw aan ‘t IJ kreeg de jarige dirigent Reinbert de Leeuw zowel de Zilveren Medaille van de stad Amsterdam als de Prins Bernhard Cultuurfonds Prijs uitgereikt.
|